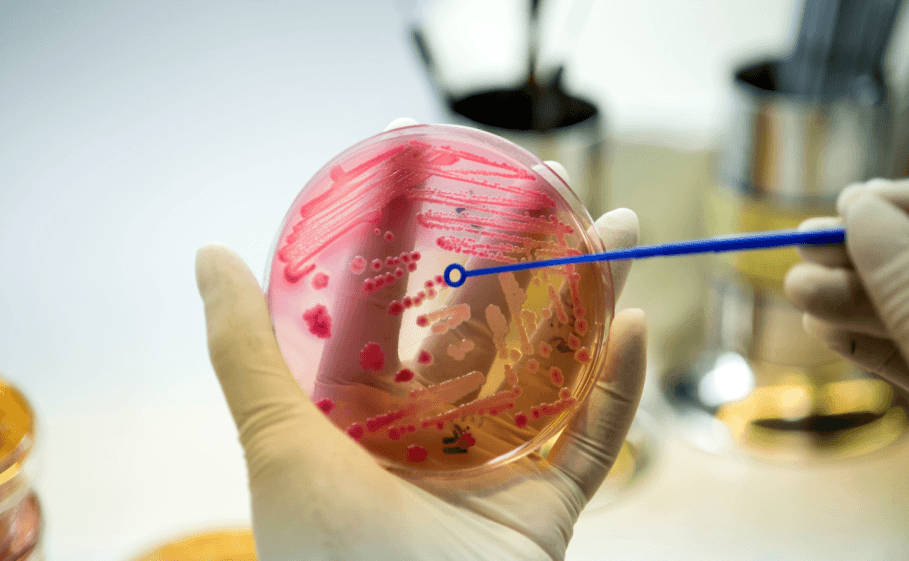

Diagnóstico Integrado — Sistema de Salud Almater, Mexicali
Más cerca de ti, más cerca de tu respuesta. Integramos radiología, laboratorio clínico, microbiología y estudios especializados en un solo sistema coordinado — para que tu diagnóstico y tratamiento lleguen con la rapidez y precisión que mereces.
Servicios Diagnósticos Especializados en Mexicali
01
01 Hematología y Coagulación
Análisis de células sanguíneas y mecanismos de coagulación — biometría hemática completa, fórmulas diferenciales, tiempos de coagulación y pruebas de función plaquetaria. Esencial para diagnóstico y seguimiento de anemias, trastornos hemorrágicos, enfermedades hematológicas y monitoreo de tratamientos anticoagulantes.

02
02 Química Sanguínea
Panel completo de análisis metabólicos que evalúa hígado, riñones, páncreas y corazón — glucosa, perfil lipídico, enzimas hepáticas, función renal, electrolitos y marcadores cardíacos. Base diagnóstica para enfermedades metabólicas, monitoreo de tratamientos crónicos y evaluaciones preventivas.

03
03 Marcadores Tumorales
Determinación de proteínas específicas producidas por células tumorales — CEA, AFP, CA 125, CA 19-9, PSA, HER2 y otros — que apoyan el diagnóstico, estadificación, evaluación de respuesta al tratamiento y seguimiento oncológico. La interpretación clínica requiere siempre evaluación por el especialista tratante.

04
04 Estudios Hormonales
Evaluación del sistema endocrino mediante medición de hormonas tiroideas, suprarrenales, reproductivas y metabólicas — TSH, T3, T4, cortisol, insulina, prolactina, FSH, LH, estradiol, testosterona y más. Fundamentales para diagnóstico de diabetes, enfermedades tiroideas, trastornos reproductivos y seguimiento de terapias hormonales.

05
05 Pruebas Especiales Oncológicas
Panel diagnóstico avanzado orientado al paciente oncológico — biomarcadores moleculares, perfiles de expresión génica, citometría de flujo y pruebas de farmacogenómica. Permiten personalizar el plan de tratamiento según las características específicas del tumor. Disponible con atención prioritaria para pacientes del Centro Oncológico Almater.

06
06 Uroanálisis y Parasitología
Evaluación integral de orina y detección de parásitos intestinales — examen general de orina, urocultivo, prueba de embarazo, examen coproparasitoscópico y detección de antígenos parasitarios. Fundamentales para diagnóstico de infecciones urinarias, enfermedad renal, parasitosis y seguimiento de tratamientos.

07
07 Microbiología Clínica
Cultivos y detección de microorganismos, pruebas de sensibilidad a antibióticos, técnicas moleculares y exámenes parasitológicos — para diagnósticos oportunos y decisiones médicas más precisas. Único en hospital privado en Mexicali.
08
08 Biología Molecular
PCR en tiempo real, secuenciación, detección de mutaciones y pruebas de resistencia antimicrobiana molecular. Identifican agentes infecciosos con alta sensibilidad, detectan alteraciones genéticas asociadas a cáncer y guían decisiones terapéuticas personalizadas.

09
09 Inmunología y Serología Infecciosa
Evaluación del sistema inmune y detección de anticuerpos — ANA, ANCA, factor reumatoide, complemento, inmunoglobulinas, serologías virales (hepatitis, VIH, CMV, EBV) y bacterianas. Clave para diagnóstico de enfermedades autoinmunes, inmunodeficiencias e infecciones sistémicas, coordinados con el servicio de Microbiología Clínica Almater.

10
10 Endoscopía de Tubo Digestivo
Evaluación y atención del aparato digestivo — esofagogastroduodenoscopía, colonoscopía, colocación de balón intragástrico y cápsula endoscópica — con acompañamiento médico cercano en cada etapa del estudio.

11
11 Radiografía Digital y Fluoroscopía
Estudios de imagen convencional con tecnología 100% digital — radiografías de tórax, abdomen, extremidades y columna, más fluoroscopia para evaluación dinámica del tracto digestivo, deglución y procedimientos guiados. Resultados digitales inmediatos disponibles en imagen.almater.mx.

12
12 Ultrasonido HD Especializado 3D/4D
Evaluación en tiempo real de órganos abdominales, pélvicos, tiroideos, vasculares y obstétricos mediante transductores de alta definición con capacidad tridimensional y tetradimensional. Sin radiación. Visualización dinámica de estructuras y del flujo vascular mediante Doppler color — fundamental para el diagnóstico gineco-obstétrico, abdominal y de tejidos blandos.

13
13 Tomografía Computarizada Multicorte
Imagen seccional de alta resolución de cerebro, tórax, abdomen, pelvis, columna y extremidades en segundos. Reconstrucciones multiplanares y tridimensionales para la evaluación de trauma, enfermedad vascular y oncología, y para la planificación quirúrgica. Disponible con o sin contraste intravenoso, según indicación médica.

14
14 Resonancia Magnética de Alta Definición
Imagen de alta resolución sin radiación ionizante para el sistema nervioso central, la columna vertebral, las articulaciones, los tejidos blandos y los órganos abdominopélvicos. Superior contraste entre tejidos blandos — fundamental en neurología, ortopedia y oncología. Requiere evaluación previa de implantes metálicos y dispositivos electrónicos.

15
15 Mamografía Digital de Baja Dosis
Detección y diagnóstico de patología mamaria con la menor dosis de radiación posible. Permite detección temprana de cáncer de mama, evaluación de microcalcificaciones y caracterización de lesiones. Recomendada anualmente a partir de los 40 años o antes según factores de riesgo individuales.

16
16 Arco en C Quirúrgico
Fluoroscopía intraoperatoria en tiempo real para reducción de fracturas, colocación de implantes, procedimientos vasculares y vertebrales. Integrado directamente al quirófano del Sistema de Salud Almater para coordinación inmediata entre imagen y cirugía.

17
17 Radiología Intervencionista Avanzada
Procedimientos diagnósticos y terapéuticos mínimamente invasivos guiados por imagen — biopsias percutáneas, drenajes, embolizaciones, vertebroplastias y accesos vasculares. Coordinados por un equipo multidisciplinario de radiólogos intervencionistas, cirujanos y oncólogos para reducir la necesidad de cirugía abierta y acelerar la recuperación.

Laboratorios de Análisis Clínicos y Microbiología — Únicos en Hospital Privado en Mexicali
Más de 1,000 tipos de pruebas especializadas, bajo estrictos controles de calidad. Cada estudio es parte de un plan más amplio, diseñado específicamente para tus necesidades de salud.


Asistente de seguros
Gestionamos tu cobertura médica para agilizar autorizaciones y reembolsos con tu aseguradora — coordinando con más de 60 aseguradoras. Para que tú solo te preocupes por tu salud. Te decimos sí, y te decimos cómo.


Familias Almater
Más de 60,000 familias mexicalenses ya tienen acceso a costos preferenciales y descuentos en estudios de laboratorio, de imagen y consultas externas — más apoyo de hasta 100% en deducible y coaseguro. Sin costo de afiliación.